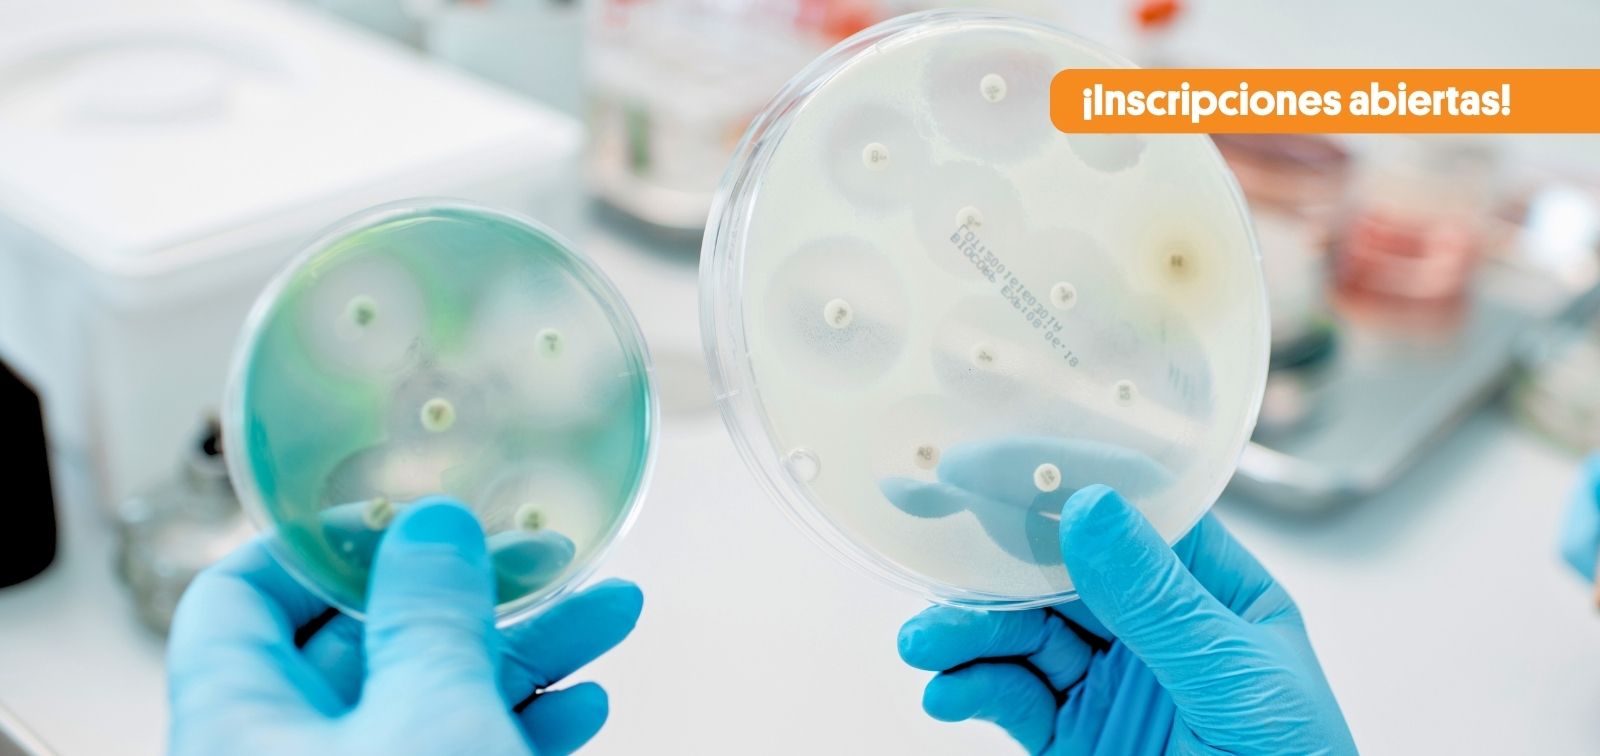

Nuestro sitio web www.isglobal.org (el “Sitio Web”) utiliza una tecnología denominada “cookies” con la finalidad de poder recabar información acerca del uso del Sitio Web.
Una cookie es un archivo que se descarga en su equipo (ordenador o dispositivo móvil) con la finalidad de almacenar datos que podrán ser actualizados y recuperados por la entidad responsable de su instalación.
La información recabada a través de las cookies puede incluir la fecha y hora de visitas al Sitio Web, las páginas visionadas, el tiempo que ha estado en nuestro Sitio Web y los sitios visitados justo antes y después del mismo.
Le informamos de que podemos utilizar cookies con la finalidad de facilitar su navegación a través del Sitio Web, proporcionarle una mejor experiencia en el uso del mismo, distinguirle de otros usuarios, e identificar problemas para mejorar nuestro Sitio Web. Asimismo, en caso de que preste su consentimiento, utilizaremos cookies que nos permitan obtener más información acerca de sus preferencias y personalizar nuestro Sitio Web de conformidad con sus intereses individuales.
La presente política de cookies tiene por finalidad informarle de manera clara y precisa sobre las cookies que se utilizan en nuestro Sitio Web (la “Política de Cookies”). En caso de que quiera recabar más información sobre las cookies que utilizamos en el Sitio Web, podrá remitir un correo electrónico a la siguiente dirección: lopd@isglobal.org.
Tipo de cookies que se usan en el Sitio Web
Nuestro Sitio Web utiliza las cookies que se describen a continuación:
Cookies propias
Son aquellas cookies que son enviadas a su ordenador y gestionadas exclusivamente por nosotros para el mejor funcionamiento del Sitio Web. La información que recabamos se emplea para mejorar la calidad de nuestro servicio y su experiencia como usuario. Estas cookies permanecen en su navegador más tiempo, permitiéndonos reconocerle como visitante recurrente del Sitio Web y adaptar el contenido para ofrecerle contenidos que se ajusten a sus preferencias.
Cookies analíticas de terceros
Si interactúa con el contenido de nuestro Sitio Web también pueden establecerse cookies de terceros (por ejemplo, al pulsar botones de redes sociales o reproducir vídeos alojados en otro sitio web). Las cookies de terceros, son aquellas establecidas por un dominio diferente de nuestro Sitio Web. No podemos acceder a los datos almacenados en las cookies de otros sitios web cuando navegue en los citados sitios web.
En nuestro Sitio Web utilizamos el sistema de medición de audiencia Google Analytics, Facebook, First Party, Twitter, Vimeo, Youtube, Instagram, Issuu y Opinion Stage. Estas herramientas nos permiten conocer cómo interactúan los usuarios de nuestro Sitio Web. Las cookies usadas se consideran “persistentes”, es decir, que los datos siguen almacenados en el terminal y pueden ser accedidos y tratados durante un periodo definido por el responsable de la cookie y que puede ir de unos minutos a varios años.
A continuación, detallamos la clasificación de las cookies según la finalidad para la que se traten los datos obtenidos:
- Cookies técnicas: aquellas que permiten al usuario la navegación a través de una página web, plataforma o aplicación y la utilización de las diferentes opciones o servicios que en ella existan como, por ejemplo, controlar el tráfico y la comunicación de datos, identificar la sesión, acceder a partes de acceso restringido, recordar los elementos que integran un pedido, realizar el proceso de compra de un pedido, realizar la solicitud de inscripción o participación en un evento, utilizar elementos de seguridad durante la navegación, almacenar contenidos para la difusión de vídeos o sonido o compartir contenidos a través de redes sociales.
- Cookies de personalización: permiten al usuario acceder al servicio con algunas características de carácter general predefinidas en función de una serie de criterios en el terminal del usuario como por ejemplo serian el idioma, el tipo de navegador a través del cual accede al servicio, la configuración regional desde donde accede al servicio, etc.
- Cookies de análisis: permiten al responsable de estas, el seguimiento y análisis del comportamiento de los usuarios de los sitios web a los que están vinculadas. La información recogida mediante este tipo de cookies se utiliza en la medición de la actividad de los sitios web, aplicación o plataforma y para la elaboración de perfiles de navegación de los usuarios de dichos sitios, aplicaciones y plataformas, con el fin de introducir mejoras en función del análisis de los datos de uso que hacen los usuarios del servicio.
- Cookies publicitarias: permiten la gestión, de la forma más eficaz posible, de los espacios publicitarios.
- Cookies de publicidad comportamental: almacenan información del comportamiento de los usuarios obtenida a través de la observación continuada de sus hábitos de navegación, lo que permite desarrollar un perfil específico para mostrar publicidad en función de este.
- Cookies de redes sociales externas: se utilizan para que los visitantes puedan interactuar con el contenido de diferentes plataformas sociales (facebook, youtube, twitter, linkedIn, etc..) y que se generen únicamente para los usuarios de dichas redes sociales. Las condiciones de utilización de estas cookies y la información recopilada se regula por la política de privacidad de la plataforma social correspondiente.
Estas cookies, junto con nuestros archivos de registro del servidor, nos permiten conocer el número total de usuarios que visitan nuestro Sitio Web y aquellas partes del mismo que gozan de mayor popularidad. Gracias a ellas obtenemos una información que puede ayudarnos a mejorar la navegación y dar un mejor servicio a usuarios y clientes.
Incluimos a continuación el enlace al sitio web de Google donde puede consultar la descripción del tipo de cookies que utiliza Google Analytics y su periodo de expiración.
Consentimiento
Al navegar y continuar en nuestro Sitio Web, estará consintiendo el uso de las cookies antes enunciadas, por los plazos señalados y en las condiciones contenidas en la presente Política de Cookies.
Deshabilitar y bloquear cookies
En cualquier caso, le informamos de que dado que las cookies no son necesarias para el uso de nuestro Sitio Web, puede bloquearlas o deshabilitarlas activando la configuración de su navegador que le permite rechazar la instalación de todas las cookies o de algunas de ellas. La práctica mayoría de los navegadores permiten advertir de la presencia de cookies o rechazarlas automáticamente. Si las rechaza podrá seguir usando nuestro Sitio Web, aunque el uso de algunos de sus servicios podrá ser limitado y por tanto su experiencia en nuestro Sitio Web menos satisfactoria.
Revocar mi consentimiento
Si quisiese revocar en cualquier momento su consentimiento relacionado con la presente Política de Cookies, deberá eliminar las cookies almacenadas en su equipo (ordenador o dispositivo móvil) a través de los ajustes y configuraciones de su navegador de Internet. Para mayor información sobre la eliminación, deshabilitación o bloqueo de las cookies por favor visite esta página.
Modificación de la configuración y ajustes sobre cookies
Salvo que haya ajustado la configuración de su navegador, nuestro sistema creará cookies en cuanto visite nuestro Sitio Web. Tenga presente que todos los navegadores de Internet permiten el cambio de dicha configuración. Para más información sobre la forma de ajustar sus configuraciones de cookies en los siguientes navegadores, le remitimos al enlace pertinente:
Internet Explorer:
Cambios en la Política de Cookies
Es posible que actualicemos la Política de Cookies de nuestro Sitio Web, por ello le recomendamos revisar esta política cada vez que acceda a nuestro Sitio Web con el objetivo de estar adecuadamente informado sobre cómo y para qué usamos las cookies. La Política de Cookies se actualizó por última vez a fecha de 6 de julio de 2018.
Contacto
Si tuviera alguna duda, comentario o sugerencia sobre la Política de Cookies, por favor escriba a la persona Delegada de Protección de Datos: lopd@isglobal.org.
[Actualizado en 11 de marzo de 2020 · Photo: Christopher Burns / Unsplash]